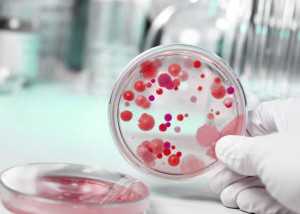

ТОП-10 свечи от молочницы (эффективные и недорогие) для женщин
Появление вагинального кандидоза в первую очередь ставит женщин перед выбором средств для терапии заболевания. Многие пациентки уже сталкивались с опытом лечения вагинального кандидоза и применяют знакомые препараты, которые помогли когда-то. А вот новички в борьбе с недугом теряются перед выбором, – какие самые лучшие свечи от молочницы, чтобы вылечить заболевание быстро и навсегда.
Лучшие свечи от молочницы: список с названиями
Лучше всего использовать суппозитории для лечения молочницы – они местно воздействуют на пораженную грибком слизистую оболочку влагалища и дают лучший результат, чем таблетки, спреи. Чтобы выбрать оптимальное средство вам было удобнее, мы составили перечень ТОП-10 противогрибковых препаратов в форме влагалищных свечей.
Макмирор
Наиболее эффективным на рынке антимикотических препаратов, по мнению врачей, является Макмирор комплекс.

Оказывает противогрибковое, антибактериальное и противопротозойное воздействие. Активное вещество – нифурател, вспомогательное – нистатин. Не конфликтуют между собой, оказывая комплексный эффект. За один сеанс больные избавляются не только от грибка, но и от болезнетворных бактерий.
Макмирор комплекс разрешено использовать даже во время беременности. Еще одно преимущество препарата в том, что, воздействуя на грибки и патогенную микрофлору, он не угнетает нормальный биоценоз влагалища, из-за чего терапия происходит максимально толерантно. Курс приема – 8 или 12 дней по одному суппозиторию на ночь.
Гино-Певарил
Относительно новый представитель антимикотической группы для борьбы с грибковым поражением гениталий.

В состав Гино-Певарил входит компонент эконазола нитрат, оказывающий губительное действие на дрожжи, грибки, дерматофиты, грамположительные микроорганизмы. Он удобен в плане дозировки – Гино-Певарил выпускаются по 50 и 150 мг. При хроническом течении заболевания курс пролонгируется, поэтому врачи назначают на две недели по 50 мг вещества ежедневно.
При остром кандидозе воздействовать на возбудителя нужно мощнее и гинекологи рекомендуют воспользоваться дозировкой 150 мг и ставить всего три штуки Гино-Певарил в течение трех ночей. Препарат хорошо переносится, но его нельзя применять у беременных в первом триместре из-за проникновения действующего вещества в системный кровоток. Практически не вызывает побочных эффектов.
Клотримазол
Хорошие свечи от молочницы по приемлемой цене – Клотримазол. В основу входит одноименное действующее вещество, губительно действующее на широкий спектр патогенных микроорганизмов, в том числе и грибков.

Принцип действия Клотримазола – нарушение жизненно важных процессов у грибкового возбудителя, из-за чего он впоследствии погибает. Несмотря на разнообразие форм выпуска, женщины уже долгое время отдают предпочтение суппозиториям Клотримазол, что доказывает эффективность и удобство их в применении.
Стандартный курс использования Клотримазола – 6 дней, в течение которых ставят по одной штуке на ночь. Учитывая тяжесть заболевания, гинекологи рекомендуют продлить срок применения.
Пимафуцин
Хороший результат в борьбе с кандида альбиканс дают свечи от кандидоза для женщин Пимафуцин. Препарат отличается демократичной ценой и высоким качеством – при помощи лекарства можно надежно вылечиться от болезни.

В основе Пимафуцина – химический компонент натамицин. Несмотря на широкое применение, резистентность возбудителя к нему не сформировалась – это позволяет постоянно получать положительный результат от терапии Пимафуцином. Применять необходимо один раз в день, на ночь, время проведения терапия – от трех до шести дней в зависимости от тяжести течения патологии.
При достижении желаемого результата врачи советуют с целью профилактики пролонгировать еще на три дня. Использовать Пимафуцин можно всем, в том числе и беременным, поскольку активный компонент не оказывает тератогенное влияние на плод.
Свечи на основе нистатина
Активное химическое вещество нистатин входит в состав сразу нескольких наименований, это и одноименные суппозитории Нистатин, и Полижинакс, и Неомицин, и Тержинан – свечи от молочницы, список которых можно продолжить.

Отличаются эти представители антимикотической группы лишь дополнительными компонентами, входящими в их состав. Нистатин противопоказан во время беременности, но показывает хорошие результаты, поэтому его часто назначают не беременным. Несмотря на свои положительные качества, не все решаются пользоваться нистатиновыми аналогами.
Свечи из нистатиновой группы используют два раза в сутки – утром и вечером, срок применения их достаточно длителен – примерно две недели. Конечно, большинство пациенток при сегодняшней фармацевтической промышленности предпочитают решать проблему за короткий срок, но нистатин станет спасительным для тех, кто имеет хронический процесс. В этом случае стоит смириться с неудобствами использования нистатина, поскольку результат превышает все ожидания.
Ливарол
Эффективный местный антимикотический представитель российского производства — Ливарол. В основе средства содержится кетоконазол, обеспечивающий фунгицидное воздействие.

Кетоконазол влияет на кандида альбиканс, на дрожжеподобных, дерматофитов, а также на стафилококки и стрептококки. Решая, какие свечи при молочнице лучше, стоит учесть – Ливарол активен как в отношении острого течения патологии, так и при хроническом, часто рецидивирующем типе заболевания. Это выгодно отличает их от других наименований. Ливарол назначают пациенткам со слабым местным иммунитетом, а также тем, у кого серьезно нарушен баланс влагалищной микрофлоры из-за длительного применения антибиотиков.
Противопоказан Ливарол при беременности в первые три месяца вынашивания плода, а также тем, кто имеет индивидуальную непереносимость кетоконазола. Для помощи Ливаролом применяют по одной штуке каждый день, вводя их на ночь поглубже во влагалище. Курс использования – не менее трех-пяти дней, а при затяжном недуге врачи рекомендуют пользоваться Ливаролом не менее 10 дней, чтобы добиться стойкого терапевтического действия.
Залаин
Венгерский представитель противогрибкового ряда Залаин стал популярным благодаря хорошему антимикотическому эффекту. Ценовая категория Залаина приемлема. В основе суппозиториев – сертаконазола нитрат.

Действующее вещество пагубно воздействует на кандида альбиканс, дерматофиты, стрептококки и стафилококки. Помимо широкого спектра действия, Залаин имеет и другие преимущества. Часто больные применяют один суппозиторий Залаин, чтобы избавиться от признаков вагинального кандидоза. При тяжелом течении болезни врачи рекомендуют повторное применение через неделю.
Отличительной позитивной характеристикой Залаина является невозможность его проникновения в системный кровоток. Это означает, что побочные реакции от использования минимальны. Лишь иногда женщины жалуются на покраснение и зуд, но такие осложнения возникают крайне редко. Также стоит отметить, что Залаин разрешен во время менструаций, чего не позволяют другие медикаменты.
Ирунин
Лучшие свечи от молочницы, которая часто рецидивирует, – Ирунин. Действующий компонент – итраконазол. Как и другие противогрибковые представители, препарат отлично действует против разных видов возбудителей.

Суппозитории вводят глубоко во влагалище на ночь, минимальный срок использования – семь дней, максимальный – две недели. Их не назначают беременным в первом триместре, а остальным рекомендуют воздержаться от половой жизни во время терапии.
При грудном вскармливании молодой маме лучше прервать кормление. В редких случаях Ирунин провоцирует побочки, среди которых зуд и жжение, но врачи не советуют прекращать прием – побочные явления быстро исчезают.
Клион-Д
Большой популярностью не так давно пользовались суппозитории Клион-Д, но с выходом более прогрессивных аналогов препарат был незаслуженно забыт.

В основе Клион-Д – активное вещество метронидазол и миконазола нитрат, обладающие противогрибковым свойством. Кроме этого свечи обладают и антибактериальным эффектом. Это особенно важно, если причина заболевания не только грибки, но и болезнетворные бактерии.
Использовать Клион-Д лучше всего на начальной стадии появления признаков вагинального кандидоза. Применять необходимо в течение десяти дней, ставя на ночь во влагалище. Если патология протекает тяжело, возможно подключение пероральных средств.
Кетоконазол
Выбирая, какие свечи от молочницы самые лучшие, нельзя обойти внимание Кетоконазол. Он содержит одноименное активное вещество, отлично борющееся против грибковых возбудителей.

Кетоконазол при попадании во влагалище быстро проникает в слизистую оболочку и работает непосредственно против возбудителя. Цена на препарат невелика, но действие от этого не ухудшается. Лечение Кетоконазолом проходит на протяжении не менее пяти дней по одной штуке каждый день.
При необходимости врачи могут продлить курс до десяти дней. Кетоконазол запрещен для применения у тех женщин, кто ждет ребенка и кормит грудью. Также его не назначают тем, кто страдает почечной или печеночной недостаточностью.
Какие свечи от кандидоза для женщин лучше выбрать?
При необходимости лечения кандидоза гениталий лучше всего обследоваться перед началом приема у врача-гинеколога и сдать рекомендованные анализы. Лабораторные исследования дадут возможность не только установить возбудителя, но и тяжесть течения процесса, наличие отягощенности анализов.
В зависимости от результатов врач назначит лучшие свечи от молочницы, названия которых спрашивают в аптеке без рецепта. При терапии в полном объеме недуг лечат за короткий срок и добиваются стойкой ремиссии.
lechenie-molochnicy.info
Самые эффективные свечи от хронической молочницы
Антимикотические суппозитории при молочнице в хронической форме являются наиболее удобными и простыми препаратами. Любое женское заболевание, которое связано с мочеполовыми органами, требует современного лечения, поскольку от этого зависит детородная функция. При инфицировании в запущенной форме увеличивается опасность формирования бездетности, а также иных серьезных осложнений.

Особенности заболевания
Молочницу вызывают грибы типа Candida, поэтому в медицине заболевание называют кандидозом. Гинекологи утверждают, что для излечения заболевания лучше пользоваться вагинальными свечами. Средства, которые воздействуют местно, характеризуются меньшим количеством побочных действий, так как действующие субстанции не всасываются в кровь, а убивают болезнетворные бактерии именно на пораженной слизистой оболочке, причем купируется воспалительный процесс и устраняется иная симптоматика молочницы. Уточним, какие свечи при хронической молочнице более эффективны.
Почему формируется заболевание
Формирование заболевания провоцируют грибки Candida. Основная масса представительниц женского пола является носителями данного грибка. При благоприятной микрофлоре во рту, кишечнике или во влагалище грибок не проявляется и совсем безвредный. Если возникает малейшее нарушение в равновесии защиты, то грибок активно распространяется по организму.
Факторы, воздействующие на развитие кандидоза у представительниц женского пола следующие:
- Стрессовое состояние, нервный срыв;
- Снижение иммунитета;
- Употребление в пищу продуктов низкого качества;
- Сахарный диабет;
- Лечение антибиотиками;
- Вынашивание ребенка;
- Нарушение гормонального фона;
- Хронические заболевания.
- Стрессовое состояние
- Снижение иммунитета
- Сахарный диабет
- Лечение антибиотиками
Симптоматика
Формирование грибковой инфекции обязательно сопровождает характерная симптоматика, о которой необходимо знать. Кандидоз у женщин проявляется следующими признаками:
- Раздражение инфицированного участка;
- Боли при половом акте и мочеиспускании;
- Выделения из влагалища, внешне схожие с творожной массой;
- Зуд гениталий внутри и снаружи.
Как лечить
Когда у представительниц женского пола диагностируют кандидоз, для ее лечения используют разные методы, к примеру:
- Назначается диетическое питание;
- Используются медикаментозные препараты;
- Применяется нетрадиционная медицина;
- Врачевание при помощи очищения кишечника.
Широко распространено лечение кандидоза при помощи медикаментозных препаратов. Благодаря ним есть возможность быстрого и надежного избавления от симптоматики болезни, а также возвращения в норму микрофлоры в детородных органах.
Подобными лекарственными препаратами являются суппозитории, крем и таблетки. Благодаря применению специализированных лекарств можно излечиться от кандидоза как на начальной форме, так и на хронической.

Отличный результат показали антимикотические свечи от хронической молочницы, отдельные суппозитории могут использоваться и для лечения беременных женщин.
При обращении в гинекологическую клинику представительница женского пола получит необходимые рекомендации относительно кратности использования и дозирования лекарственного препарата, которые обусловлены стадией диагностированной болезни. Зачастую для лечения заболевания в хронической форме используют комплексную терапию, а лекарства, которые применяются, должны действовать именно на очаг инфекции.
Эффективные и недорогие
Среди недорогих и эффективных суппозиториев, которые используются для лечения хронического кандидоза, выделяют следующие.
Нистатин
Один из самых первых дешевых антимикотических препаратов при кандидозе. Действующая составляющая – нистатин, характеризующаяся фунгицидной активностью по отношению к дрожжевым грибкам Candida и быстро устраняющая симптоматику кандидоза. У грибка не вырабатывается резистентность к данному лекарству, по этой причине Нистатин назначается при повторном развитии молочницы, а также недуге, который протекает в хронической стадии. Такие суппозитории используются по врачебным рекомендациям два раза в течение суток, длительность лечения составляет от 10 дней до 2-х недель.
К противопоказаниям к использованию препарата относится повышенная чувствительность к составляющим, а также беременность.
При лечении возможно проявление таких побочных эффектов: болей в животе, расстройства стула, тошноты, рвоты и озноба. По этой причине женщинами чаще используются новые комплексные лекарственные средства, в основе которых нистатин – к ним относятся суппозитории Тержинан и Полижинакс. Эти лекарства характеризуются меньшим количеством побочных действий, однако они могут вызвать развитие дисбактериоза. По этой причине, по окончании курсовой терапии рекомендуют использовать свечи, содержащие лактобактерии.
Клотримазол

Одни из недорогостоящих вагинальных суппозиториев, которые используются при молочнице, для них характерен широкий спектр действия. Действующая составляющая лекарства – клотримазол (вторичный имидазол) помогает бороться как с дрожжевыми грибками, так и с иными болезнетворными бактериями (дерматофитами, диморфными грибками). Средство зачастую назначается для комплексного лечения вагинальных инфицирований (молочницы, вульвагинита).
Клотримазол используется для лечения кандидоза в течение шести суток по одной свече перед сном. Противопоказан суппозиторий беременным (в особенности до 3-х месячного срока), в лактационный период, а также при аллергической реакции на составляющие лекарства. Во время лечения могут проявиться такие побочные эффекты, как зуд, жжение, головная боль, дискомфорт внизу живота, частое мочеиспускание. Главный недостаток данного медикамента в том, что грибок быстро привыкает к действующей составляющей, что приводит к значительному снижению эффекта.
Кетоконазол (подобие Ливарола)
Противогрибковый препарат с широким спектром функционирования, основан на действующей составляющей с одноименным названием. Показывает неплохие результаты как в борьбе с грибковой микрофлорой, так и со стафилококками и стрептококками. Эти суппозитории назначаются при лечении молочницы в острой или хронической стадии. А также используют в качестве профилактических действий, чтобы предотвратить иные грибковые инфекции во влагалище, которые формируются при антибиотикотерапии и нарушают микрофлору в половых органах.
Рекомендуется использовать 1 свечу в течение дня. Курс лечения – 3-5 суток. Противопоказан препарат беременным и при гиперчувствительности к составляющим лекарства. В некоторых случаях может проявиться аллергия, гиперемия и зуд во влагалище.
Эффективные
Многие недорогие лекарства от кандидоза медики используют уже не один год, по этой причине к некоторым средствам у болезнетворных грибков выработалась устойчивость.
Однако фармацевтика не стоит на месте и появляется все больше лекарств, обладающих меньшим количеством побочных действий. Они лучше воспринимаются организмом и дают лучший результат при лечении кандидоза. В настоящее время даже появились свечи для вагинального использования, которые приносят необходимый эффект после однократного применения. Среди них выделяют следующие суппозитории.
Залаин
Эффективное антимикотическое средство для одноразового использования. Упаковка содержит одну свечу, которую советуют применять на ночь. Единственным противопоказанием к использованию Залаина является гиперчувствительность. Свечи назначаются даже беременным, кормящим матерям и при месячных.
Суппозитории рекомендованы, чтобы лечить молочницу и кандидозный вульвовагинит. В редких случаях возможно проявление побочных действий, таких как зуд и жжение, проходящие быстро и без посторонней помощи. Большим преимуществом является высокий эффект и вероятность излечить за одни сутки симптоматику кандидоза, а также применение свечей при месячных. Единственным недостатком является высокая цена препарата.

Ломексин
Суппозитории от кандидоза в виде капсулы для одноразового использования. Для препарата характерны антимикотические и антимикробные свойства. Действующая составляющая лекарства – фентиконазол. Для свечей свойственно эффективное уничтожение болезнетворных бактерий, причем без всасывания в кровь и без побочных эффектов.
В случае сохранения признаков заболевания после использования свечи, спустя трое суток вводится еще одна капсула. Лекарство неплохо переносится и в редких ситуациях возможно раздражение на краткое время.
Эти свечи противопоказаны беременным и при аллергической реакции на составляющие лекарства.
Пимафуцин
Еще один современный антимикотический препарат с небольшим количеством ограничений к использованию. Суппозитории назначаются беременным, и их неплохо переносят пациентки. Редко могут проявляться побочные действия в виде небольшого раздражения. Единственное ограничение к использованию суппозиториев – аллергическая реакция на действующую составляющую – натамицин. Также свечи не используются при месячных. Лечение этим препаратом длится трое суток, такая терапия позволяет полностью справиться с симптоматикой молочницы.
антимикотический препарат с небольшим количеством ограничений к использованию. Суппозитории назначаются беременным, и их неплохо переносят пациентки. Редко могут проявляться побочные действия в виде небольшого раздражения. Единственное ограничение к использованию суппозиториев – аллергическая реакция на действующую составляющую – натамицин. Также свечи не используются при месячных. Лечение этим препаратом длится трое суток, такая терапия позволяет полностью справиться с симптоматикой молочницы.
Миконазол
Средство с множеством аналогов, таких как Микозон, Гинезол, Клион Д-100 и другие. Все они являются комбинированными медикаментами, которые основаны на антимикотической составляющей миконазол и антибиотике метронидазол. Довольно популярными среди этих препаратов являются таблетки для вагинального использования Клион Д, быстро справляющиеся даже с кандидозом в запущенной форме. Таблетка смачивается в воде и вводится во влагалище на ночь. Курсовая терапия составляет 10 суток.
Препараты, действующая составляющая которых миконазол, используют при терапии кандидоза и вагинита смешанного вида. Производятся в двух лекарственных формах: свечах и таблетках для вагинального использования. Эта группа лекарств обладает большим количеством ограничений к использованию: повышенная чувствительность, вынашивание ребенка, кормление грудью, болезни печени, влагалищный герпес, аллергия на составляющие.
Макмирор

Антимикотическое средство, в основе которого нистатин и нифурател. В упаковке содержится 8 свечей для вагинального использования. Они вводятся один раз в сутки на ночь. Единственное противопоказание – индивидуальная непереносимость. Суппозитории могут использоваться для лечения от молочницы беременных. В редких случаях возможно проявление зуда либо высыпаний на кожных покровах. У лекарства имеется один недостаток – высокая стоимость.
Бетадин
Действующая составляющая средства – повидон-йод, характеризующийся дезинфицирующими и антисептическими свойствами и эффективным уничтожением многих бактерий, грибков, вирусов и простейших микроорганизмов. Свечи назначаются для лечения смешанного вагинита, молочницы и бактериального вагиноза.
Препарат характеризуется множеством ограничений к использованию. Он противопоказан, если нарушена работа щитовидной железы, повышена чувствительность к йоду, имеется тиреотоксикоз, почечная недостаточность, при вынашивании ребенка и кормлении грудью. При терапии может проявиться аллергия и местная гиперемия. Данные суппозитории могут использоваться при менструациях. Обычно назначается для лечения кандидоза по 2 свечи в течение дня на протяжении 10-14 суток.
Лечение кандидоза с помощью суппозиториев должно осуществляться точно по аннотации к лекарству. При отсутствии улучшения спустя несколько суток после начала использования необходимо проконсультироваться с врачом, чтобы он подкорректировал лечение или назначил более эффективный препарат.
помощью суппозиториев должно осуществляться точно по аннотации к лекарству. При отсутствии улучшения спустя несколько суток после начала использования необходимо проконсультироваться с врачом, чтобы он подкорректировал лечение или назначил более эффективный препарат.
Лечение беременных с помощью суппозиториев
При беременности в организме у будущей мамы происходят перемены по подготовке к материнству, а также меняется количество гормонов. В это время у женщины ухудшается работа иммунной системы и происходит обострение многих хронических недугов, включая частое повторение кандидоза.
В это время многие лекарства запрещены, поскольку могут нанести вред развивающемуся плоду путем нарушения правильного формирования. В особенности с осторожностью необходимо лечиться в первые три месяца беременности. Хотя есть суппозитории для лечения кандидоза, которые могут использоваться даже в первые 12 недель вынашивания ребенка. К этим лекарствам относятся:
- Залаин;
- Натамицин;
- Пимафуцин;
- Макмирор;
- Примафунгин.
- Залаин
- Пимафуцин
- Макмирор
- Примафунгин
По окончании первого триместра, после обязательной консультации у специалиста, могут быть назначены следующие антимикотические лекарства:
- Клотримазол;
- Нистатин;
- Румизол;
- Гино-Певарил;
- Тержинан.
Суппозитории для лечения кандидоза в лактационный период подбираются так, чтобы действующая составляющая не проникала в молоко матери. Это свечи, для которых характерно низкое системное поглощение: Пимафуцин, Залаин, Макмирор и другие. Главное, что их обязательно должен назначать доктор.
Достоинства и недостатки суппозиториев
Позитивный момент в применении суппозиториев для лечения молочницы – быстрое лечебное действие. Местное средство при попадании на слизистую во влагалище быстро убивает возбудителя грибкового инфицирования и устраняет малоприятную симптоматику кандидоза.
Главное достоинство этих препаратов – минимальное всасывание действующих составляющих в кровь, благодаря чему практически не формируются системные побочные эффекты. Еще одно преимущество – современные лекарства, которые предназначены для одноразового использования, позволяют после введения одного суппозитория устранить признаки заболевания.
Недостатком при местной терапии является неудобное использование суппозиториев, есть возможность протекания, как следствие пачкается нижнее бельё. К тому же во время лечения необходимо отказаться от половых контактов. Некоторые суппозитории помогают лишь при кандидозе в легкой форме, а при тяжелом инфицировании необходимо дополнительное использование антимикотических средств в таблетированной форме.
Помимо этого, если пользоваться комбинированными лекарствами, которые имеют в составе антибиотик, возможен дисбактериоз во влагалище. По этой причине курсовое лечение должно закончиться дополнительным использованием суппозиториев с лактобактериями, чтобы восстановить микрофлору во влагалище.
Правильное использование
Главные требования по использованию свечей для влагалища следующие:
- Вводить свечи лучше на ночь, чтобы потом не приходилось подниматься;
- Суппозитории для лечения кандидоза должны вводиться глубоко во влагалище;
- Чтобы избежать протеканий, защищайте нижнее бельё прокладкой;
- При лечении придется совершенно отказаться от сексуальных контактов;
- Курсовое лечение при вагинальной молочнице нужно пройти как представительнице женского пола, так и ее сексуальному партнеру;
- При лечении кандидоза не пользуйтесь нижним бельем из синтетических тканей;
- При терапии кандидоза откажитесь от спиртного, острого и соленого;
- Не совмещайте терапию с помощью суппозиториев с иными лекарствами без назначения специалиста.
Если соблюдать вышеназванные советы, то можно получить наилучший терапевтический результат, быстро избавиться от молочницы и предотвратить возможный рецидив недуга.
gribokube.ru
Свечи или таблетки от молочницы — что лучше выбрать?
Молочница — самая распространенная проблема, с которой обращаются к гинекологу. Происходит это потому, что ее возбудителями являются микроорганизмы, которые присутствуют в организме большинства людей (причем не только у женщин, но и мужчин).
Этот грибок ведет себя скромно, пока наша защитная система держит его в узде. Но стоит иммунитету ослабнуть, как он начинает активно размножаться и негативно действовать на слизистую влагалища. Наиболее частыми симптомами молочницы являются обильные, похожие на творог выделения, из-за чего нарушение и получило свое название. Многие женщины вдобавок к этому испытывают дискомфорт в области половых органов, усиливающийся при половом акте и мочеиспускании.

Важно помнить, что подобные симптомы могут сигнализировать о более серьезных воспалительных процессах, поэтому для точной диагностики следует обратиться к специалисту. Если вынесен ясный вердикт, что всему виной грибы рода Candida, то следующим шагом станет выбор лечения. На сегодняшний день существуют два основных метода борьбы с молочницей: свечи и таблетки. Как они действуют и что эффективнее?
Свечи от молочницы
Вагинальная свеча — средство местного действия. Она представляет собой суппозиторий округлой формы, предназначенный для введения внутрь. Твердая при комнатной температуре свеча, попадая во влагалище, растворяется под действием тепла и равномерно распределяется по слизистой.

Активное вещество снижает разросшуюся популяцию грибков и ликвидирует неприятные симптомы. Перед использованием стоит промыть влагалище теплой водой при чрезмерных выделениях. Для необходимого эффекта следует ввести суппозиторий достаточно глубоко внутрь. Существуют специальные аппликаторы для облегчения этой процедуры.
Как и другие виды свечей, это лекарство должно храниться при температуре не выше 25°С. В стандартной упаковке находится 5-10 штук.
Таблетки от молочницы
Противогрибковые препараты выпускаются и в более привычной форме таблеток или капсул. У некоторых наименований есть также порошок для суспензии. Их действие более глобально, они применяются не только при вагинальном, но и других формах кандидоза.

Что общего между ними
В разных формах может выпускаться одно и то же лекарство или препарат с одинаковым действующим веществом. На отечественном фармацевтическом рынке встречаются следующие активные компоненты:
- Нистатин.
- Натамицин (Пимафуцин).
- Кетоконазол (Ливарол, Низорал).
- Миконазол (Микозон).
- Эконазол.
- Сертаконазол (Залаин).
- Клотримазол (Кандид, Канизон).
- Фентиконазол (Ломексин).
- Бутоконазол (Гинофорт).
- Флуконазол (Флюкостат, Микосист, Дифлюкан, Дифлазон, Микофлюкан, Форкан, Микомакс).
- Итраконазол (Ирунин, Итразол, Орунгал, Румикоз).
- Повидон-йод (Бетадин).
К сожалению, обе формы лечения объединяет один минус — грибок умеет к ним приспосабливаться. Например, повсеместное использование лекарств на основе флуконазола привело к тому, что микроорганизмы просто научились ему противостоять. Поэтому наряду с мазком влагалища, который выявляет молочницу, появился новый гинекологический анализ, который проверяет к чему резистентны ее возбудители. Его результаты прямо влияют на выбор препарата.
Чем они отличаются
- Таблетки имеют более широкий спектр действия. В среднем ограничения их применения выше по сравнению с противопоказаниями к использованию вагинальных свечей.
- Из-за местного воздействия вагинальные свечи работают точечно. Они меньше затрагивают другие системы организма, наводя порядок непосредственно в очаге воспаления.
- Многие препараты, выпускаемые в форме капсул, представляют собой разовую дозу. При первичной, ничем не осложненной молочнице достаточно один раз выпить лекарство. Уже через сутки наступит заметное облегчение, а через неделю дискомфорт совершенно исчезнет. При хроническом воспалении процесс лечения растягивается на период от 3 до 7 дней.
- Большинство вагинальных свечей нужно применять только раз в сутки в течение 5-7 дней, хотя иногда курс растягивается на 2 недели. Оптимальным периодом для этого считается ночь — после введения придется лежать. Суппозиторию требуется время, чтобы полностью раствориться во влагалище, — это длится около получаса. После этого допустимо вытекание вещества наружу, поэтому для комфорта можно воспользоваться прокладками.
- На протяжении всего периода использования вагинальных свечей пациентке показан половой покой. Также для лечения придется выбрать определенные дни цикла — менструальные выделения и изменение уровня кислотности во влагалище снижают эффективность некоторых препаратов.
- Очевидно, что свечи могут применять только женщины. Но доказано, что молочница может быть следствием половых контактов. Пероральная форма препарата ликвидирует повышенную активность грибка у мужчин и позволит избежать рецидива без использования презервативов.
Что, когда и для кого лучше?
Если неприятность настигла впервые, оптимальным способом будет применение разовой капсулы для обоих партнеров или таблетка для мужчины и курс суппозиториев для женщины. Однако гинекологи часто назначают сразу оба вида средств — для пущей эффективности. Особенно это касается запущенных форм молочницы (с которой обращаются чаще всего после безуспешных попыток самолечения).
Также таблетки могут стать продолжением курса, если применение свечей не оказало должного эффекта.
Молочница — частый гость во время беременности. Как и в случае с прочими лекарствами, применять противогрибковые средства необходимо в соответствии с противопоказаниями. Например, препараты, содержащие нистатин и флуконазол, будущим матерям использовать нельзя, зато Пимафуцин, Тержинан и Ливарол не имеют таких ограничений. Остальные лекарства обладают разными свойствами, в зависимости от которых их нужно применять с оглядкой на текущий триместр беременности.
vchemraznica.ru
Свечи от молочницы — какие эффективнее принимать
Свечи от молочницы — эффективное решение неудобной проблемы. Действие указанных препаратов обусловлено тем, что активное вещество быстро проникает в слизистую влагалища, при этом полностью уничтожается возбудитель болезни. На сегодня медицинская промышленность выпускает различные свечи против молочницы. Необходимо рассмотреть, какие есть влагалищные суппозитории для терапии вагинального кандидоза, чем обусловлены особенности их действия и случаи назначения.
Общие указания
Свечи (суппозитории) — ряд препаратов, позволяющих в краткие сроки излечить молочницу (кандидоз). Свечи при молочнице у женщин применяют интравагинально, таким образом можно уничтожить возбудителя заболевания и снизить интенсивность воспалительного процесса. Все свечи от молочницы, список которых представлен в аптеках, отличаются по своей эффективности и степени воздействия на грибок, однако их действие направлено именно на то, чтобы убить микроорганизм, притом желательно за несколько сеансов.
Для оказания наилучшего эффекта необходимо, чтобы действующий компонент был наиболее активным в отношении патогенов. Чтобы выбрать максимально действенное средство, перед тем как начать лечение, необходимо обратиться к специалисту. Он проведет бактериологическое обследование вагинальных мазков. На основании результатов можно будет рассуждать о названии препарата против молочницы.
Очень важно внимательно выбирать средство от хронической молочницы. В таком случае грибок уже приобрел некоторую резистентность. Так что отдельные медикаменты против такого грибка могут быть малоэффективными. Все же на рынке существуют лекарственные препараты, которые будут активными и в отношении этого вида кандидоза. В лечении надо ориентироваться не на собственный опыт и рекомендации знакомых, которым, возможно, помогло то или иное средство, а на результаты обследований.
Итак, какие свечи от молочницы лучше? Если патология только лишь появилась и ее симптомы не слишком выраженные, то можно использовать эффективные суппозитории Ливарол, Клотримазол и др. Инструкция по применению таких препаратов указывает, что медикаменты помогают быстро и основательно избавиться от кандидоза.

С помощью современных препаратов можно вылечить даже самый устойчивый вид недуга. Для этого применяется Кетоконазол и другие медикаменты, специально разработанные для воздействия на самые резистентные и агрессивные штаммы грибков Кандида. Будьте внимательны: самостоятельно применять такие суппозитории не рекомендуется. Только врач может рекомендовать их. Более того, для недопущения развития дисбиоза необходимо дополнительно лечиться специальными препаратами. Они содержат пробиотики, восстанавливающие микрофлору.
Фармакодинамика и фармакокинетика суппозиториев
Действующие компоненты таких свечей активны в отношении большого количества грибков. Они могут проявлять воздействие и в отношении стафилококков, стрептококков и других патогенных микроорганизмов.
Все активные компоненты суппозиториев превосходно справляются с проявлениями острых и рецидивирующих разновидностей вагинального кандидоза. Свечи в основном применяются интавагинально, хотя есть и такие лекарственные формы, которые могут вводиться в прямой кишечник. При нормальной температуре тела они быстро растворяются в организме. Во влагалище или в прямой кишке через некоторое время образуется пенообразная масса. Она хорошо распределяет по слизистой оболочке активное вещество.
Некоторые суппозитории могут содержать в своем составе цетиловый алкоголь. В ряде случае он способен стать причиной аллергических болезней, поэтому перед каждым применением таких препаратов необходимо проконсультироваться с врачом-гинекологом. В ряде случаев следует прекратить половую жизнь. Запрещено использовать данные медикаменты и в период вынашивания ребенка.
Противогрибковые компоненты нарушают целостность клеточной мембраны вредителя. Такой процесс быстро приводит к гибели организма. Активный компонент суппозитория быстро выводится из организма почками.
Как необходимо применять суппозитории
Некоторые женщины считают, что им подойдет любой противогрибковый препарат и даже антибиотик. Их решение простое — немедленно пойти в аптеку, купить «какое-нибудь» средство против кандидоза и начинать его принимать, желательно большими дозами, чтобы патология прошла «сейчас же». Такое лечение молочницы ни к чему хорошему не приводит, так как способствует переходу заболевания в хроническую форму. Некоторые женщины и вовсе практикуют спринцевание, что при таком недуге очень опасно.
Так что лучшие свечи от молочницы — те, которые максимально действуют на возбудителя и при этом не нарушают полезной микрофлоры. А это возможно только после бактериологического посева мазков. Вот почему самолечение вагинального кандидоза чрезвычайно опасно.
Применяя вагинальные свечи от молочницы, женщина должна позаботиться и о том, чтобы такое же заболевание лечил ее партнер. У мужчин тоже бывает молочница, однако она в большинстве случаев протекает без симптомов. В результате представитель сильного пола является носителем такой болезни. Во время лечения надо либо отказываться от интимных контактов, либо применять презервативы. Вагинальные свечи от кандидоза вводят глубоко, на ночь (это улучшает всасывание активного вещества и результаты терапии).
Во время лечения не нужно носить синтетическое тесное белье. Необходимо тщательно соблюдать все предписания половой гигиены. Нижнюю одежду надо менять ежедневно. Запрещено применять ароматизированные прокладки, в которые добавлены химические вещества. В таких случаях даже самые эффективные свечи от молочницы не помогают.
Обзор лучших препаратов против молочницы
На сегодня фармацевтическая промышленность выпускает огромное количество медикаментов против кандидоза. Необходимо рассмотреть отдельные препараты для лечения заболевания:
- Залаин. Является производным имидазола и бензотиофена. Данных о том, вредно ли такое средство для плода, сегодня нет. Категорически противопоказано применение препарата при гиперчувствительности. Может вызывать зуд во влагалище и жжение. Ставятся такие свечи на ночь.
- Ливарол (Кетоконазол) — эффективное противогрибковое средство. В первом триместре беременности не применяется. Может вызывать сыпь, иногда — крапивницу. Эффект от использования свечей наступает практически сразу же — они помогают при остром кандидозе. Длительный (более 10 дней) прием препарата допустим только при хронической форме болезни. Свечи лучше ставить на ночь. Средство может быть эффективным при рецидивирующих формах кандидоза.
- Интраконазол не применяется в первом триместре, при гиперчувствительности, во время грудного вскармливания. Лечение данными свечами, как правило, непродолжительное.
- Нистатин — один из медикаментов, который может использоваться во время беременности. Его единственный недостаток — довольно высокая цена. Очень редко при применении Нистатина возникает сыпь, зуд кожи и пр.
- Клотримазол — качественное и действенное средство для женщин, страдающих кандидозом. Противопоказаниями являются повышенная чувствительность и беременность в первом триместре. Свечка может вызывать такие побочные явления, как жжение во влагалище, зуд, цистит, боль во время коитуса. Лекарство имеет один существенный недостаток — в случае продолжительного использования возникает резистентность (устойчивость) грибков к активному компоненту.
- Миконазол — эффективные свечи при молочнице, это комбинированное средство против кандидоза. Его нельзя применять при беременности и сахарном диабете. Во время терапии запрещено употребление спиртного.
- Повидон йод — свечи, содержащие йодоксин и повидон. Запрещено применять при тиреотоксикозе, заболеваниях почек. Очень осторожно употребляется во время грудного вскармливания. Может вызвать аллергию.
- Ломексин — действенное средство против кандидозного вагинита. При индивидуальной непереносимости препарата и во время беременности применение таких суппозиториев запрещено.
Преимущества и недостатки применения суппозиториев
Препараты для лечения молочницы, конечно же, имеют преимущества. Среди них следующее:
- Если в место размножения грибков вводится активное средство, то результат появляется очень быстро. Это особенно актуально при использовании самых новых препаратов для лечения кандидоза.
- Есть такие препараты, которые можно применять 1 раз. Это снижает вероятность развития побочных явлений.
- Свечи для лечения этого заболевания не имеют системного действия. А это намного лучше, чем пероральные средства против вагинального кандидоза.
Все же противогрибковые свечи имеют определенные недостатки:
- Пачкают нижнее и постельное белье, приводят к ограничению половой жизни. Поэтому некоторые пациентки не желают использовать такие лекарства.
- Хороший эффект достигается только в том случае, если кандидоз имеет легкую форму. Для лечения хронической молочницы таких свечей недостаточно. Их необходимо комбинировать с системными препаратами. Более того, необходимо повторять курс лечения.
- Часто комбинированные свечи для терапии молочницы у женщин могут привести к вагинальному дисбактериозу. Он требует дальнейшего антибактериального лечения.
Применение свечей во время беременности
Молочница в период беременности возникает очень часто. Однако при таком кандидозе применять некоторые препараты противопоказано. Все же для устранения патологии в такой период подходят следующие медикаменты:
- Пимафуцин свечи (в них содержится активное вещество пимафуцин).
- Макмирор — комбинированный препарат (с действующими веществами нистатин и нифурател).
- Клотримазол (во втором или третьем триместре обладает сниженной активностью).
- Смесь буры и глицерина.
- Гинофорт.
- Тержинан. По мнению некоторых специалистов, применение Тержинана с преднизолоном в качестве активного вещества нежелательно и допустимо только в том случае, если ожидаемая оценка положительного воздействия на организм выше, чем возможный риск использования такого лекарственного препарата.
Ректальные суппозитории
Для лечения молочницы врач может назначить свечи, которые применяются ректально. Они помогают при кишечном или вагинальном дисбактериозе. Их можно ставить в период вынашивания ребенка или же во время менструации. Названия некоторых средств, применяемых в указанных случаях:
- Виферон. Это комплексный препарат. Описание лекарства говорит о том, что средство обладает антивирусным, антипролиферативным и иммуностимулирующим действием. Показания для его применения — инфекционные или воспалительные урогенитальные патологии, профилактика внутриутробного заражения. Им можно лечить вагиноз, герпетическую инфекцию, хламидиоз. Такие свечи могут применяться только по назначению врача. Срок терапии в ряде случаев — до 2-х недель. При беременности допустимо использование только с 14 недели.
- Нистатин для ректального применения — эффективное средство против неприятной болезни. Это название свечей от молочницы известно женщинам, страдающим рецидивирующим кандидозом. Лекарство плохо всасывается, и его основная масса выделяется с фекалиями. Им можно лечить кандидоз вагины, кожи, рта, некоторых внутренних органов. Лекарство эффективно и для предупреждения развития такого заболевания в случае длительного употребления антибактериальных препаратов, особенно тетрациклинового и пенициллинового ряда.
Пимафуцин обладает широким спектром действия. Доказана высокая чувствительность грибков рода Кандида к такому препарату. Суппозитории могут назначаться и для терапии кандидоза органов пищеварительного тракта. Положительно воздействует на возбудителей грибковых патологий. Такие суппозитории ставятся в основном на ночь.

Общие противопоказания и побочные эффекты
Все противопоказания к применению суппозиториев зависят то того, какое именно действующее вещество есть в их составе. Так, если у женщины диагностирован кандидоз, свечи вагинального введения противопоказаны в период менструации. Тогда надо пользоваться ректальными суппозиториями. Большое число таких препаратов может быть запрещено во время беременности в том или ином триместре.
Серьезное противопоказание к применению вагинальных суппозиториев в период беременности — это индивидуальная непереносимость. Если у женщины диагностирована молочница, свечи подбираются только врачом на основании тщательного обследования. Запрещено применять ароматизированные гигиенические вещества, которые значительно ухудшают симптоматику болезни.
Обычно побочные явления при правильном применении вагинальных суппозиториев возникают довольно редко. Это связано с тем, что свечи — лекарство местного действия. Побочные эффекты могут быть в основном в виде зуда, сыпи или гиперемии (то есть напоминают аллергическую реакцию).
Некоторые разновидности таких свечей способны вызывать и более тяжелые побочные эффекты:
- диарею;
- запор;
- озноб;
- гипертермию.
Чтобы устранить неприятные явления, необходимо уменьшить дозировку вводимого лекарства. После того как оно будет отменено, все нежелательные признаки пройдут сами собой в течение 3-х суток. Как правило, симптоматическое лечение не рекомендуется, потому что неприятное состояние устраняется самостоятельно.
За время применения данных лекарств не было зарегистрировано случаев передозировки, так как их форма в принципе исключает это. Все же если женщина применяет свечи в излишних дозировках, то у нее могут значительно усиливаться побочные действия. Они проходят после коррекции объема препарата.
Все свечи для лечения вагинального кандидоза способствуют быстрому избавлению от нежелательных симптомов. Для того чтобы усилить воздействие активных веществ на патоген, врачи могут назначать вагинальные таблетки от молочницы. Чтобы такое избавление было наиболее эффективным, очень важно правильно использовать свечи и лишь по назначению специалиста, так как самолечение во время вагинального кандидоза категорически противопоказано.
stopmol.ru
Лекарства от молочницы у взрослых: какие препараты эффективные?
Чтобы вылечить молочницу, потребуется несколько видов препаратов, направленных не только на уничтожение возбудителя, но и на снятие зуда и восстановление микрофлоры. Почему врачи при такой, казалось бы, простой болезни назначают так много разнообразных препаратов?
Какие лекарства от молочницы самые хорошие? Что лучше: таблетки или свечи против молочницы? Вопросов много и все именно из-за того, что недуг нам кажется несерьезным и на его излечение не хочется тратить много усилий и средств, и зря.

Невылеченная острая форма заболевания становится хронической, и без ответственного подхода к болезни недуг будет тревожить вас всю жизнь. Как же правильно лечить кандидоз?
Виды медицинских препаратов для лечения молочницы
Кандидоз – распространенное грибковое заболевание не только у женщин, но и у мужчин. Проблематичность заболевания в том, что его многие считают сродни насморку и вообще не лечатся или же лечение кандидоза происходит без консультаций с доктором.
Внимание! Лечение молочницы обязательно должно быть системным, где назначаются не только местные препараты в виде свечей, кремов или мазей, но и таблетки с противогрибковым или комбинированным действием.
Возможна ситуация, что свечи или мазь будет куплена без рецепта, но таблетки противопоказано употреблять без назначений специалиста. Нельзя утверждать, что именно свечи – лучшее лекарство против молочницы, так как при разных течениях заболевания требуется разный комплекс лекарств.
Если врач назначает и свечи, и таблетки, и средства народной медицины, то и нужно лечиться комплексно, а не выбирать что-то одно. Важно значение имеет и соблюдение правильного питания и во время курса лечения, и вообще, чтобы избегать проявлений болезни снова.
Таблетки от кандидоза для взрослых
Все противогрибковые таблетки против молочницы будут давать эффект, если препарат будет назначаться после полного обследования и доктору получится выявить первопричину болезни. При назначении определенных таблеток учитывается не только состояние больного, но и многие другие факторы.

Самыми результативными препаратами считаются таблетки, в составе которых есть флуконазол:
- дифлюкан;
- флюкостат;
- дифлазон;
- форкан;
- медофлюкон;
- микосист и некоторые другие.
Все эти медикаменты способны быстро подавить развитие грибка и вылечить болезнь в острой форме даже при разовом приеме. Если же кандидоз хронический, то не приходится надеяться на моментальное излечение и таблетки с флуконазолом придется принимать длительный период. Важно понимать, что вагинальные таблетки не излечивают недуг навсегда и кандидоз всегда может дать рецидив.
Внимание! Таблетки от молочницы с флуконазолом имеют большой список противопоказаний, поэтому самолечение недопустимо. В первую очередь их нельзя употреблять беременным и кормящим грудью женщинам и пациентам с болезнями печени и почек. Будьте ответственны!
Особенности лечения молочницы у мужчин
Таблетки от молочницы у мужчин такие же, как и для лечения женщин, но лечение мужского кандидоза имеет ряд особенностей. Мужчина заболевает при ослабленном иммунитете, и чаще всего это происходит после серьезной болезни и длительного приема антибиотиков, поэтому в основе лечения – иммуномодулирующая терапия.

Современные лекарства от молочницы эффективны и практически не имеют побочных эффектов, и не секрет, что многие женщины принимают их без консультаций врача и считают, что имеют право рекомендовать определенные таблетки своим партнерам, что абсолютно неприемлемо. Самолечение мужского кандидоза недопустимо!
Перед доктором стоит ответственная задача предельно правильно назначить больному курс лечения, чтобы укрепить защитные функции мужского организма и при этом никоем образом ему не навредить.
Внимание! Результат от лечения будет только в том случае, если больной будет полностью соблюдать все предписания врача и не принимать назначенные препараты выборочно. Важно понимать, что при приеме противогрибковых и комплексных лекарств противопоказан алкоголь даже в самых небольших дозах.
Вагинальные свечи от молочницы
Лекарственные препараты в виде суппозиториев (свечей) достаточно эффективны, если начать их ставить при первых же признаках болезни. По отзывам большинства женщин, страдающих часто повторяющимся кандидозом, что если лечение свечами при молочнице начиналось у них сразу же, то уже через 2-3 дня неприятный зуд и жжение полностью прекращались.
Для лечения хронического кандидоза у женщин врачи в зависимости от симптоматики и проявлений болезни рекомендуют следующие вагинальные свечи:
- пимафуцин;
- полижинакс;
- клотримазол;
- нистатин;
- ливарол;
- кетоконазол;
- бетадин;
- клион-Д;
- тержинан;
- гинезол;
- гино-дактинол.
В связи с тем, что имеющиеся в аптеках свечи для лечения кандидоза у женщин, имеют достаточно разный состав и в результате оказывают разное влияние на проблему, то их принимать нужно только после консультаций с гинекологом, а не довольствоваться советами фармацевта или подруг.
Не забывайте, что полностью вылечить молочницу не получится, если не соблюдать диету, ведь многие продукты постоянно будут провоцировать ее возникновение снова.
Свечи от молочницы при беременности
Пимафуцин в озвученном выше списке стоит на первом месте не случайно, так как этот препарат полностью безопасен, не имеет противопоказаний и его можно использовать при лечении женщин, ждущих малышей.
Беременным женщинам крайне важно не затягивать с лечением кандидоза, ведь если его не излечить до начала схваток, то во время родов плод может инфицироваться и у новорожденного будет молочница во рту, что очень опасно для его здоровья и жизни.

Свечи пимафуцин назначают беременным, так как данный препарат:
- никак не влияет на плод;
- не токсичен и не аллергичен;
- достаточно быстро выводится из женского организма.
Некоторые женщины испытывают некий дискомфорт от применения свечей, но это происходит от несоблюдения инструкций. Чтобы был эффект от вагинальных свечей от молочницы, их нужно ставить так, как советуется в инструкции и делать надо это перед самым сном.
7rubrik.com
Какие свечи наиболее эффективны в борьбе с молочницей?
 Какие эффективные средства от молочницы предлагает фармацевтика? Удобным в использовании и результативным способом борьбы с влагалищным кандидозом, по мнению современных гинекологов, являются свечи.
1
Какие эффективные средства от молочницы предлагает фармацевтика? Удобным в использовании и результативным способом борьбы с влагалищным кандидозом, по мнению современных гинекологов, являются свечи.
1Каковы преимущества использования свечей от молочницы?
Преимуществами препаратов в виде свечей являются:
- простота введения суппозитория во влагалище;
- высокий процент усвоения лекарственных средств на грибковую инфекцию;
- целенаправленная борьба с симптомами молочницы;
- использование во время беременности и грудного вскармливания.

Первыми симптомами поражения влагалища грибковой инфекцией можно назвать зуд, жжение, резь во время полового акта и обильные творожистые выделения. В аптеках встречаются противогрибковые препараты общего и местного применения. Иногда допускается использование вагинальных свечей в качестве монотерапии, в запущенных и хронических формах свечи от кандидоза и молочницы являются частью комплекса, где присутствуют и противогрибковые средства в виде таблеток.
Кандидоз – коварное и сложное в лечении заболевание, именно поэтому перед началом терапии женщине следует пройти комплексное обследование, выявить возбудителя инфекции, определить степень чувствительности грибков и устойчивость их путем бактериального посева. Только врач имеет право назначить эффективные свечи от молочницы, основываясь на результатах обследования.
2Каковы тонкости лечение молочницы с помощью свечей?
В рамках обследования гинекологу предстоит определить индивидуальные особенности организма пациентки. Некоторые факторы способствуют прогрессированию молочницы, переходу ее в хроническую форму. Это: диета, ряд хронических заболеваний, гормональный дисбаланс, ослабленный иммунитет, прием антибиотиков.
Четкое соблюдение подобранной гинекологом схемы лечения и дозировки противогрибковых свечей от молочницы – основополагающая успешной борьбы с инфекцией. Практика показывает, что снижение дозировки становится причиной развития и распространения кандид, приводит к прогрессированию болезни и переходу в хроническую форму. Лечение осложняется наличием инфекций, передающихся половым путем. Кандидоз нередко сопровождается хламидиозом, гонорей, трихомониазом и другими инфекциями. Поэтому интенсивность проявления симптомов, клиническая картина заболевания и результаты общего обследования у гинеколога должны стать основой курса терапии.

Одновременное лечение обоих половых партнеров – еще одно условие лечения молочницы. Мужчины являются переносчиками инфекции, болезнь в их случае может протекать бессимптомно. Вероятность повторного заражения после полового контакта с инфицированным мужчиной велика. Поэтому во время лечения молочницы свечами лучше отказаться от половых контактов или использовать презервативы. Уделите внимание нижнему белью: откажитесь от синтетического, плотно обтягивающего белья, регулярное ношение которого создает идеальную среду для развития бактерий. Соблюдение элементарной интимной гигиены с ежедневной сменой белья и полотенца, отказ от парфюмированных косметических средств, ежедневных прокладок – те простые правила, которых должны придерживаться все девушки, желающие раз и навсегда избавиться от воспаления и инфекции.
Важно с первого дня лечения использовать только качественные свечи от кандидоза для женщин, во время покупки уточнять срок годности, интересоваться составом, противопоказаниями, возможными побочными действиями. Некоторые пациентки, начитавшись отзывов на женских форумах, занимаются самолечением, практикуют спринцевания от кандидоза на основе лекарственных трав без консультации с гинекологом. Подобные действия нарушают микрофлору влагалища, становятся причиной прогрессирования болезни.
Каждая женщина должна понимать серьезность заболевания, необходимость своевременной консультации с гинекологом. На практике самолечение приводит к негативным последствиям, проявляющимся в развитии дисбактериоза, формировании хронического кандидоза, нарушении гормонального баланса.
3Какими бывают свечи от молочницы?
Вагинальные свечи от молочницы: препараты на основе флуконазола, нистатина, а также клотримазола. Критерий градации – активный компонент лекарственного средства, действие которого направлено на уничтожение бактерий гриба. Комплексные свечи при молочнице у женщин представлены Полижинаксом и Тержинаном. Гинекологи особым образом подходят к назначению препарата, отталкиваясь от контингента пациентки. Существуют свечи от молочницы при беременности и для кормящих женщин, свечи для детей, в том числе грудничков, а также пациенток, страдающих заболеваниями внутренних органов.

Широчайший ассортимент противогрибковых препаратов, представленных современным фармакологическим рынком, помогает подобрать наиболее эффективную программу лечения в каждом конкретном случае. Поэтому назначать свечи для лечения молочницы должен только гинеколог.
4Свечи от молочницы на основе натамицина
Представляют собой современные противогрибковые препараты местного применения, где активным компонентом выступает антибиотик полиенового ряда – натамицин. Компоненты оказывают целенаправленное действие на клеточные мембраны грибов, нарушая их обменные процессы, тем самым замедляя рост и дальнейшее распространение. Яркими представителями данной группы являются: Пимафуцин, Натамицин и Примафунгин.

Пимафуцин представлен в виде удобных в использовании влагалищных свечей, демонстрирует местное действие. Препарат не противопоказан беременным и кормящим женщинам. Продолжительное и бесконтрольное использование, как и любого другого антибиотика, становится причиной дисбактериоза влагалища. Важно соблюдать выбранную схему лечения, пидерживатся дозировки, рекомендованной лечащим специалистом. Суточная норма – по одному суппозиторию на ночь. Препарат вводят во влагалище в положении лежа: свеча вводится максимально глубоко и остается во влагалище на ночь. Рецидив заболевания — основание для назначения дополнительного препарата. Чаще это таблетки с содержанием натаномицина, помогающие уничтожить очаг инфекции в кишечнике и других внутренних органах. В качестве профилактики молочницы гинекологи рекомендуют использовать препараты на основе того же активного компонента, например, в виде крема.
Противопоказанием использования вагинальных свечей с содержанием натамицина является общая непереносимость антибиотиков данной группы или конкретно активного вещества. В этом случае специалист должен подобрать другое средство.
5Свечи от молочницы на основе клотримазола
Яркими представителями недорогих свечей от молочницы являются: Клотримазол, Кандибене, Кандизол, Кандил В6, а также Антифунгол и Йенамазол 100. Свечи с клотримазолом для лечения молочницы оказывают направленное действие на клетки грибов, изменяя их структуру и свойства. В результате этого и происходит гибель главного возбудителя инфекции. Зачастую для повышения эффективности вагинальных свечей гинекологи рекомендуют использовать в качестве дополнительной терапии крема, растворы и мази с содержанием клотримазола. Среди противопоказаний присутствуют:
- повышенная чувствительность к активным компонентам состава;
- период менструации;
- первый триместр беременности.

Некоторые пациентки в процессе лечения наблюдают побочные эффекты, проявляющиеся в зуде, дискомфорте, небольшом отеке слизистой половых органов, боли во время мочеиспускания и полового акта, болевыми ощущениями в области живота, мигренью.
Эффективность действия вагинальных свечей от зуда и грибковой инфекции на основе клотримазола существенно сокращается при одновременном использовании свечей с содержанием нистатина, натамицина. Поэтому важно корректировать дозировки и продолжительность использования каждого лекарственного средства.
6Свечи от молочницы на основе флуконазола
Дешевые свечи от молочницы представлены препараторами с содержанием флуконазола: их можно найти в каждой аптеке. Это: Дифлюкан, Флюзак, Флуконазол, Флюкостат, Медафлюкон и другие. Чаще всего это свечи от молочницы однократного применения. Флуконазол – триазольный противогрибковый препарат, получивший широкое распространение в современной медицине. Механизм его работы базируеься на нарушении процесса синтеза в клетках грибов, что постепенно приводит к их полному разрушению и подавлению. Свечи Флуконазол – самый распространенный на сегодняшний день препарат, который назначают гинекологи. Побочные эффекты маловероятны, некоторые пациентки отмечают вялость, слабость, сонливость. Чаще всего их появление связано с превышением суточной дозировки, бесконтрольным применением препарата. Категорически запрещено пользоваться свечами от молочницы на основе флуконазола в следующих случаях:
- наличие аллергической реакции на любые компоненты состава средства;
- беременность и грудное вскармливание;
- наличие заболевания сердечнососудистой системы;
- наличие заболеваний печени и желчного пузыря.
 7
7Свечи от молочницы на основе нистатина
Свечи Нистатин от молочницы – яркий представитель продуктов данной группы. Его могут дополнять Макмирор, Полижинакс и Тержинан. Нистатин – противогрибковое вещество, демонстрирующее свою эффективность в борьбе с хронической формой кандидоза. Длительное использование препаратов данной группы может стать причиной дисбактериоза влагалища. На практике препараты могут похвастаться высокой эффективностью, отсутствием побочных эффектов. Противопоказаниями к использованию являются:
- аллергия на определенные компоненты состава;
- беременность, грудное вскармливание;
- заболевания желудочно-кишечного тракта.
 8
8Свечи от молочницы на основе кетоконазола
Представителями группы являются препараты Ливарол и Кетоконазол. Это противогрибковые вагинальные свечи с высоким содержанием кетоназола, оказывают противовоспалительное действие, изменяя липидный состав мембраны клеток гриба, угнетая и уничтожая их. Свечи, обогащенные содержанием кетоконазола, могут назначаться беременным женщинам только после первого триместра беременности, в противном случае велика вероятность развития патологических отклонений у малыша. Курс лечения в среднем продолжается от 3 до 10 дней. Продолжительность курса в первую очередь связана со сложностью заболевания. Побочные эффекты выявляются в редких случаях, почему используют свечи для профилактики молочницы. Иногда женщину могут беспокоить головные боли, зуд и незначительное жжение, в редких случаях симптомы дополняются выделениями из влагалища с неприятным запахом. Высокую эффективность препарат демонстрирует в борьбе со стафилококком, используется для лечения вагинита и вагиноза.
Лучшие свечи от молочницы – те, что уничтожают грибковую инфекцию и препятствуют ее повторному появлению. Назначить лекарственный препарат в праве только гинеколог после комплексного обследования организма и состояния пациентки. Результативность лекарственного средства индивидуальна. Ни в коем случае не пренебрегайте визитом к гинекологу, ведь самолечение приводит к провоцированию инфекции и развитию осложнений. Только квалифицированный подход помогает в борьбе с коварной грибковой инфекцией, препятствует дальнейшему распространению прогрессированию и рецидиву.
ВЭффективные свечи от молочницы
miksturka.info
Свечи от молочницы, какие выбрать хорошие недорогие эффективные вагинальные свечи против молочницы: список, названия
Как известно, молочница может возникнуть ввиду целого ряда причин, начиная от проблем, обусловленных гормональным фоном, и заканчивая длительным приемом (или просто неправильным подбором) антибиотиков. Как ни парадоксально, но эти, подчас незначительные, причины зачастую служат толчком к неконтролируемому росту колоний грибка Кандида, являющегося возбудителем этого заболевания.
Что касается самой молочницы, то свое название заболевание получило из-за специфичных, неприятно пахнущих выделений из влагалища, обладающих белым цветом и творожистой консистенцией. Помимо выделений, пациентку, заболевшую молочницей, может мучить сильный зуд, а также болезненные ощущения при мочеиспускании и во время полового акта.
В случае игнорирования лечения молочницы она переходит в скрытую форму, характеризующуюся стертой симптоматикой во время ремиссий и вышеописанными симптомами во время обострений. И, конечно же, молочница не является тем заболеванием, лечение которого можно отложить на долгие годы.
Как лечить молочницу?
Несмотря на то, что на сегодняшний день существует огромное количество средств, направленных на лечение молочницы, наиболее подходящими из них считаются свечи от молочницы, позволяющие в кратчайшие сроки справиться с этим заболеванием. Почему именно свечи? Все достаточно просто.
Современные свечи против молочницы не нарушают структуру слизистых влагалища, не раздражают ее и обладают местным действием, направленным исключительно на очаг инфекции, причем помимо противогрибковых составляющих в состав подобных свечей включены и антибактериальные, и противовоспалительные средства. И, конечно же, подобный состав позволяет весьма быстро устранить симптоматику и причину заболевания.
Стоит ли заниматься самолечением?
Вполне естественно, что страдающим от молочницы женщинам хотелось бы приобрести недорогой и эффективный препарат, мгновенно избавляющий от всей неприятной и болезненной симптоматики. Нужно понимать, что подобного препарата в мире просто не существует, а для лечения потребуется и посещение врача, и прохождение соответствующих анализов, и определенное время. Однако какие свечи от молочницы предпочесть, чтобы лечение было максимально эффективным?
Прежде всего, необходимо учитывать, что лечить молочницу самостоятельно нельзя. Свечи должны быть назначены врачом соответствующего направления на основании бакпосева и чувствительности возбудителя заболевания к тому или иному препарату.

Обуславливается это, прежде всего, тем, что рецидивирующая хроническая молочница, наиболее часто встречающаяся у женщин, характеризуется устойчивостью грибка к применявшимся ранее противомикозным препаратам. Вполне естественно, что в подобных условиях использование свечей от молочницы, назначенных без предварительных исследований, может не только не принести пользы, но и привести к нарушению микрофлоры влагалища и, соответственно, еще большим проблемам со здоровьем.
Более того, столкнувшись с тем, что приобретенные ими самостоятельно вагинальные свечи от молочницы совсем не помогают, пациентки, как правило, переходят к другим крайностям, например, самостоятельно назначают себе процедуры по спринцеванию, что легко может спровоцировать дальнейшее прогрессирование заболевания и еще большие проблемы с микрофлорой влагалища.
Следовательно, самолечение молочницы чаще всего не только неэффективно, но и опасно. Именно поэтому назначать лечение в этом случае должен только дипломированный специалист. Только врач на основании клинической картины, анамнеза заболеваний и жизни пациентки, анализа чувствительности возбудителя заболевания к тем или иным медикаментозным средствам сможет назначить адекватную терапевтическую схему.
И, конечно же, следует помнить, что полным клиническим выздоровлением считается не полное исчезновение неприятной и болезненной симптоматики, а отсутствие грибка в мазке, взятом из влагалища, причем подобные исследования во избежание рецидива должны проводиться еще на протяжении последующих 3-х месяцев после полного излечения.
Какие свечи от молочницы предпочесть?
В настоящее время существует множество свечей от молочницы, отличающихся друг от друга диапазоном действия, дозировкой и сроком, на протяжении которого их можно использовать. В зависимости от принципа действия свечи от молочницы разделяют на несколько групп:
- противогрибковое воздействие;
- комбинированное воздействие;
- заживляющее воздействие;
- антисептики;
- иммуностимуляторы;
- лактобактерии.
Противогрибковые свечи от молочницы
Противогрибковые свечи от молочницы имеют в своем составе одно или несколько из следующих веществ:
- Нистатин;
- Натамицин;
- Клотримазол;
- Кетоконазол;
- Сертаконазол;
- Миконазол;
- Итраконазол и т.п.
Подобные свечи оказывают прямое воздействие на грибок и полностью уничтожают его. Причем достаточный для излечения терапевтический курс в данном случае не превышает 7 дней. При рецидивирующем хроническом кандидозе курс повторяется через 1 неделю.
Комплексные препараты для лечения молочницы
Комплексные свечи от молочницы представляют собой суппозитории, в состав которых включены как минимум 2 вещества разного действия, что позволяет бороться как с грибками, так и с сопутствующим им бактериальным поражением. Использовать подобные свечи нужно строго по назначению врача, применяя для лечения смешанных грибково-бактериальных инфекций. В противном случае эффект от лечения будет не сопоставим с вредом, нанесенным полезной влагалищной микрофлоре.
Антисептики при лечении молочницы
Как явственно следует из названия, антисептики обладают антисептическим воздействием и препятствуют развитию на слизистой оболочке влагалища бактерий и грибков рода Кандида. Наиболее характерными представителями этой группы являются свечи от молочницы на основе йода – Йодосепт, Йодоксид, Бетадин.
Иммуностимуляторы при лечении молочницы
В качестве средств, поднимающих иммунитет, при лечении молочницы применяют свечи Виферон, предназначенные для ректального введения. Терапия препаратами подобного типа у женщин носит укрепляющий характер и производится в качестве поддерживающей терапии, увеличивающей эффективность противогрибковых или средств комбинированного действия при молочнице. Кроме того, подобные средства широко используются в целях профилактики, позволяя избежать как молочницы, так и множества заболеваний вирусного характера, что связано с активацией не только местного, но и общего иммунитета.
Ректальные свечи вводятся по одной на протяжении 5-ти дней вне зависимости от наличия менструаций. При необходимости курс лечения может быть повторен через 14 дней. Также лечение свечами от молочницы данного типа очень эффективно при поражении грибком нижних отделов кишечника. Причем в данном случае препарат одинаково эффективен как для женщин, так и для мужчин.
Лактобактерии как способ лечения молочницы
Лечение свечами от молочницы, содержащими лактобактерии, производится только тогда, когда лечение грибка полностью завершено. Объясняется это, прежде всего, тем, что подобные препараты не угнетают молочницу и используются совершенно в других целях. В каких? Попробуем разобраться.
Как уже было сказано ранее, большинство свечей от молочницы не только воздействует на грибок, но и угнетает полезную микрофлору влагалища, что, в свою очередь, приводит к тому, что освободившиеся в ходе лечения ниши вновь заселяют болезнетворные бактерии и грибки. Для того, чтобы этого не произошло, используются свечи с лактобактериями, позволяющие восстановить нормальную микрофлору и препятствующие появлению новых патогенных микроорганизмов.
Восстанавливается микрофлора, уничтоженная в ходе лечения молочницы, чаще всего свечами Ацилакт и их аналогами, воздействующими непосредственно на слизистую и существенно сокращающими время реабилитации. Однако следует помнить, что лечение подобными свечами должно быть начато только тогда, когда полностью закончено лечение антибиотиками. В противном случае кислая среда, созданная лактобактериями, станет отличным местом для размножения Кандид, вызывающих молочницу.
Наиболее популярные свечи от молочницы
Вполне естественно, что препаратов, позволяющих справиться с молочницей, в настоящее время выпускается огромное множество. Однако, как и в любой другой индустрии, в области фармацевтики существуют средства, ввиду различных факторов пользующиеся большей популярностью, чем все остальные. Рассмотрим некоторые из них более подробно.
Пимафуцин. Пимафуцин от молочницы представляет собой наиболее доступное, безопасное и эффективное средство, не вызывающее аллергических реакций и побочных действий. Именно поэтому подобные свечи без проблем могут использоваться беременными пациентками. Кроме того, действующее вещество этого препарата воздействует не только на грибки, но и множество других болезнетворных бактерий.
Ливарол. Свечи от молочницы Ливарол зачастую назначается врачами на начальных стадиях заболевания, так как Ливарол позволяет эффективно снять зуд и раздражение, а также снизить количество выделений и избавиться от неприятного запаха из влагалища. Свечи Ливарол воздействуют очень мягко, не иссушают слизистую влагалища и не оказывают подавляющего воздействия на полезную микрофлору.
Клотримазол. Пожалуй, наиболее дешевые свечи от молочницы — клотримазол, доступные широкому потребителю. Стоимость лечения в данном случае будет зависеть от степени запущенности заболевания и, соответственно, от количества свечей в упаковке.
Так, например, для лечения только начавшейся молочницы может потребоваться всего 10 свечей. Этого количества хватит для лечения заболевания на протяжении 5-ти дней – при условии применения свечей утром и вечером (в соответствии с инструкцией). Несмотря на низкую стоимость, свечи Клотримазол являются одним из наиболее эффективных препаратов от молочницы. Основным противопоказанием для использования данных свечей является беременность пациентки, так как препарат содержит гормональные составляющие.
Нистатин. Как правило, свечи Нистатин используются тогда, когда заболевание перешло в хроническую форму, так как данный препарат лучше остальных способен справиться с заболеванием, ставшим постоянным спутником женщины. Однако следует помнить, что данный препарат может подавлять и полезную микрофлору влагалища, а потому его двухнедельное применение должно быть дополнено также и курсом поддерживающих препаратов.
Свечи от молочницы для беременных
Как известно, основным требованием, предъявляемым к лекарствам для беременных, является их нетоксичность. Касается это и вагинальных свечей. Исходя из этих соображений беременным, жалующимся на зуд и творожистые выделения, могут быть назначены свечи от молочницы Пимафуцин или же вагинальные таблетки Тержинан. И тот, и другой препарат абсолютно безвредны, а потому могут использоваться и при беременности, и в период лактации, не вызывая при этом ни дисбактериоза, ни аллергии.
Что касается способа использования, то и то, и другое средство рекомендуется использовать 1 раз в сутки, перед сном: это позволит свести к минимуму дискомфорт во время сна.
Можно ли использовать свечи Гексикон для лечения молочницы?
Свечи Гексикон являются комплексным препаратом, позволяющим справиться не только с грибковыми заболеваниями, но и с болезнями, передающимися половым путем (например, с гонореей или трихомониазом). Также Гексикон широко используется и в целях профилактического лечения после незащищенного полового акта – в данном случае они вводятся во влагалище не позднее, чем через 2 часа после сексуального контакта, и позволяют справиться с возможным заражением.
Однако же при молочнице свечи Гексикон малоэффективны ввиду своей излишней агрессивности к любым видам бактерий, в том числе и полезным бактериям здоровой микрофлоры влагалища. Таким образом, Гексикон может помочь при молочнице, но при этом слишком велика вероятность скорого рецидива заболевания, и поэтому врачи избегают назначения данного препарата при молочнице.
venerologiya.ru